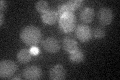
YPL172C
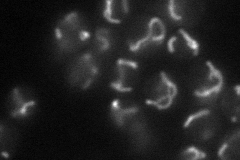
YPL172C
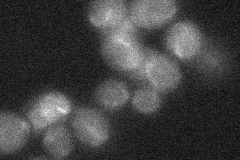
YPL172C
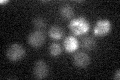
YPL172C

View description
Heme A:farnesyltransferase, catalyzes the first step in the conversion of protoheme to the heme A prosthetic group required for cytochrome c oxidase activity; human ortholog is associated with mitochondrial disorders
Localization:
Intensity:
Fold change:
Significance:
-
C’ GFP library in SD
mitochondria15.35 -
N' NOP1pr-GFP in SD
mitochondria41.2001 -
N' TEF2pr-mCherry in SD

mitochondria54.1353 -
N' NATIVEpr-GFP in SD
mitochondria17.3709 -
N' TEF2pr-VC and Cyto-VN in SD

#N/A0 -
C’ GFP library in SD+DTT

mitochondria16.151.05No -
C’ GFP library in SD+H2O2

mitochondria15.210.99No -
C’ GFP library in Starvation Media
mitochondria17.591.14No -
C’ GFP library on the background of Pup2-DaMP

mitochondria -
C’ GFP library on the background of CCT mutant

mitochondria15.00130.977209No
